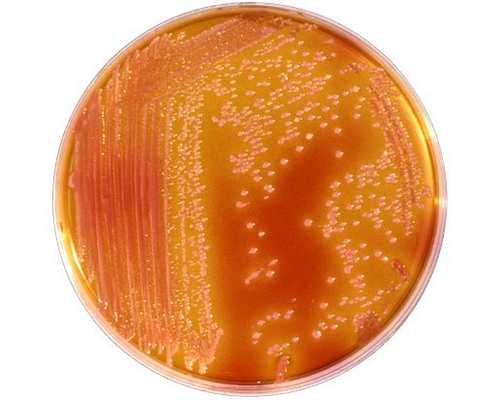
Serratia

Антибиотики для лечения энтерококковых (Enterococcus spp.) раневых инфекций. Резистентность к ванкомицину
Добавил пользователь Евгений Кузнецов Обновлено: 11.12.2025
Актуальность. Enterococcus spp. — условно-патогенные возбудители внебольничных и госпитальных инфекций, которые в последние годы расценивают как угрозу общественному здоровью в связи с их антимикробной резистентностью, в первую очередь к гликопептидам.
Цель. Определение распространенности различных видов энтерококков — возбудителей инфекций у госпитализированных пациентов и их резистентности к антибактериальным препаратам.
Методы исследования включали в себя определение видовой принадлежности энтерококков методом MALDI-TOF масс-спектрометрии и определение их чувствительности к антибактериальным препаратам в соответствии с рекомендациями EUCAST или, при их отсутствии, CLSI.
Результаты. Определили видовой состав и антимикробную резистентность 1562 последовательных штаммов, выделенных у госпитализированных пациентов в крупном медицинском центре, аккумулирующем пациентов из различных регионов Российской Федерации в 2019 г. Выявили преобладание видов E.faecalis и E.faecium (99,5%), частота выделения первого на 56% превышала частоту выделения последнего. Е.аvium, Е.casseliflavus, E.gallinarum, E.durans изолировали из 0,5% биологических проб. Наибольший уровень резистентности энтерококков наблюдали к эритромицину (84,8%), тетрациклину (75,0%) и рифампицину (68,2%). Мультирезистентность и резистентность к ванкомицинy были характерны преимущественно для E.faecium. Все выделенные из крови изоляты E.faecium были мультирезистентны. Устойчивость к ванкомицину у энтерококков, обусловивших развитие инфекций кровотока, наблюдали исключительно у 19,5% E.faecium, все ванкомицинорезистентные изоляты были устойчивы к тейкопланину. Резистентность к линезолиду выявили у 2 внебольничных штаммов E.faecalis (0,1%). Редкие виды энтерококков демонстрировали разнообразные паттерны антимикробной резистентности.
Заключение. Среди энтерококков — возбудителей инфекций у госпитализированных пациентов превалируют виды E.faecalis и E.faecium. Мультирезистентность и устойчивость к ванкомицину характерны преимущественно для E.faecium, особенно для штаммов — возбудителей инфекций кровотока. Необходимо проведение дальнейшего мониторинга распространения различных видов энтерококков в госпитальных и внебольничных условиях с определением их видовой принадлежности и антимикробной резистентности валидными методами.
Ключевые слова
Раскрытие информации о конфликте интересов:
Авторы заявляют об отсутствии конфликта интересов.
Информация о статье:
Депонировано (дата): 02.01.2022
Все авторы прочитали и одобрили окончательную рукопись статьи.
Информация о рецензировании:
"Антибиотики и Химиотерапия" благодарит анонимного рецензента (рецензентов) за их вклад в рецензирование этой работы.
Комментарий редакции:
В случае возникновения разночтений в тексте или расхождений в форматировании между pdf-версией статьи и её html-версией приоритет отдаётся pdf-версии.
Об авторах
ФГБУ «Национальный медицинский исследовательский центр им. В. А. Алмазова» Министерства здравоохранения Российской Федерации
Россия
Баранцевич Наталья Евгеньевна — научный сотрудник
eLIBRARY: SPIN-код: 3914-4499; Author ID: 785835. Scopus Author ID: 55880381000
Волкова Светлана Владимировна — заведующая клинической микробиологической лабораторией
Зарицкий Андрей Юрьевич — д. м. н., профессор, директор Института онкологии и гематологии
Баранцевич Елена Петровна — д. м. н., заведующая научно-исследовательским отделом микробиологии и внутрибольничных инфекций
eLIBRARY SPIN-код: 3534-1010. AuthorID: 268934. Scopus Author ID: 6601955793. WOS Research ID: S-1455-2016
Список литературы
2. Hollenbeck B.L., Rice L.B. Intrinsic and acquired resistance mechanisms in enterococcus. Virulence. 2012; 3 (5): 421-433. doi: 10.4161/viru.21282.
4. Suppli M., Aabenhus R., Harboe Z.B., Andersen L.P., Tvede M., Jensen J.U. Mortality in enterococcal bloodstream infections increases with inappropriate antimicrobial therapy. Clin Microbiol Infect. 2011; 17 (7):1078-1083. doi: 10.1111/j.1469-0691.2010.03394.x.
5. Billington E.O., Phang S.H., Gregson D.B., Pitout J.D., Ross T., Church D.L. et al. Incidence, risk factors, and outcomes for Enterococcus spp. blood stream infections: a population-based study. Int J Infect Dis. 2014; 26:76-82. doi: 10.1016/j.ijid.2014.02.012.
7. CLSI Performance Standards For Antimicrobial Susceptibility Testing. 29th Ed. CLSI guideline M100. Wayne, PA: Clinical and Laboratory Standards Institute; 2019.
8. Goh H.M.S., Yong M.H.A., Chong K.K.L., Kline K.A. Model systems for the study of Enterococcal colonization and infection. Virulence. 2017 Nov 17; 8 (8): 1525-1562. doi: 10.1080/21505594.2017.1279766.
10. European Centre for Disease Prevention and Control. Antimicrobial resistance in the EU/EEA (EARS-Net) — Annual Epidemiological Report 2019. Stockholm: ECDC; 2020.
12. Manero A., Blanch A.R. Identification of Enterococcus spp. with a biochemical key. Appl Environ Microbiol. 1999; 65 (10): 4425-4430. doi:10.1128/AEM.65.10.4425-4430.1999.
13. Angeletti S., Lorino G., Gherardi G., Battistoni F., De Cesaris M., Dicuonzo G. Routine molecular identification of enterococci by gene-specific PCR and 16S ribosomal DNA sequencing. J Clin Microbiol. 2001; 39 (2):794-797. doi:10.1128/JCM.39.2.794-797.2001.
14. Stępień-Pyśniak D., Hauschild T., Różański P., Marek A. MALDI-TOF Mass Spectrometry as a Useful Tool for Identification of Enterococcus spp. from Wild Birds and Differentiation of Closely Related Species. J Microbiol Biotechnol. 2017; 27 (6): 1128-1137. doi: 10.4014/jmb.1612.12036.
15. Дехнич А.В., Кречикова О.И., Туркова Л.И., Страчунский Л.С. Энтерококковое носительство и антибиотикорезистентность в отделении выхаживания недоношенных новорождённых. Клиническая микробиология и антимикробная химиотерапия. 2001; 3 (1): 28-38.
16. Soheili S., Ghafourian S., Sekawi Z., Neela V.K., Sadeghifard N., Taherikalani M. et al. The mazEF toxin-antitoxin system as an attractive target in clinical isolates of Enterococcus faecium and Enterococcus faecalis. Drug Des Devel Ther. 2015; 9: 2553-2561. doi: 10.2147/DDDT.S77263.
17. Hamada Y., Magarifuchi H., Oho M., Kusaba K., Nagasawa Z., Fukuoka M. et al. Clinical features of enterococcal bacteremia due to ampicillinsusceptible and ampicillin-resistant enterococci: An eight-year retrospective comparison study. J Infect Chemother. 2015 Jul; 21 (7): 527-530. doi: 10.1016/j.jiac.2015.04.001.
18. Sattari-Maraji A., Jabalameli F., Node Farahani N., Beigverdi R., Emaneini M. Antimicrobial resistance pattern, virulence determinants and molecular analysis of Enterococcus faecium isolated from children infections in Iran. BMC Microbiol. 2019; 19 (1): 156. doi: 10.1186/s12866-019-1539-y.
20. Zhang Y., Du M., Chang Y., Chen L.A., Zhang Q. Incidence, clinical characteristics, and outcomes of nosocomial Enterococcus spp. bloodstream infections in a tertiary-care hospital in Beijing, China: a four-year retrospective study. Antimicrob Resist Infect Control. 2017; 6: 73. Published 2017 Jul 4. doi: 10.1186/s13756-017-0231-y.
21. Tian Y., Yu H., Wang Z. Distribution of acquired antibiotic resistance genes among Enterococcus spp. isolated from a hospital in Baotou, China. BMC Res Notes. 2019; 12 (1): 27. doi: 10.1186/s13104-019-4064-z.
22. Růžičková M., Vítězová M., Kushkevych I. The characterization of Enterococcus genus: resistance mechanisms and inflammatory bowel disease. Open Med (Wars). 2020; 15: 211-224. doi: 10.1515/med-2020-0032.
23. Ramos S., Silva V., Dapkevicius Md.L.E., Igrejas G., Poeta P. Enterococci, from Harmless Bacteria to a Pathogen. Microorganisms. 2020; 8 (8):1118. doi: 10.3390/microorganisms8081118.
24. Parameswarappa J., Basavaraj V.P., Basavaraj C.M. Isolation, identification, and antibiogram of enterococci isolated from patients with urinary tract infection. Ann Afr Med. 2013; 12 (3): 176-181. doi: 10.4103/1596-3519.117629.
25. Сидоренко С. В., Тишков В. И. Молекулярные основы резистентности к антибиотикам. Успехи биологической химии. 2004; 44: 263-306.
Энтерококки
Темой сегодняшнего разговора будут одни из наиболее распространенных микроорганизмов из семейства Enterobacteriaceae - энтерококки, которые являются грамположительными кокками и факультативными анаэробами.
Материалы предназначены исключительно для врачей и специалистов с высшим медицинским образованием. Статьи носят информационно-образовательный характер. Самолечение и самодиагностика крайне опасны для здоровья. Автор статей не дает медицинских консультаций: клинический фармаколог — это врач только и исключительно для врачей.
Автор: Трубачева Е.С., врач - клинический фармаколог

Микробиологические аспекты
Энтерококки входят в состав нормальной микрофлоры кишечника, обитают в основном в тонкой кишке и при этом, обнаруживаясь за пределами своей естественной среды обитания, являются возбудителями множества социально-значимых заболеваний. Наибольшее клиническое значение имеют E.faecalis и E.faecium.
Отличительным свойством энтерококков является их способность к образованию биопленок. О биопленках достаточно подробно мы рассуждали в статье, посвященной синегнойной палочке. И специфика течения многих заболеваний, вызванных энтерококками, объясняется именно пленкообразованием.
Клинические аспекты
Наиболее частым возбудителем внебольничных инфекций является E.faecalis - сюда относятся инфекции мочевыводящих путей и инфекционные эндокардиты у внутривенных наркозависимых пациентов.
E.faecium наиболее часто выявляется при нозокомиальных инфекциях - здесь преобладают так же инфекции мочевыводящих путей, но связанные с проведением инструментальных методов исследования, а также всевозможные виды бактеремий, связанных с медицинскими вмешательствами.
Когда мы можем думать о состояниях, вызванных энтерококками?
- Менингиты, как следствие черепно-мозговых травм, нейрохирургических вмешательств и при наличии антомических дефектов центральной нервной системы
- Перитониты любой этиологии
- Пельвиоперитониты (в составе микст-флоры)
- У пациентов с диабетической стопой
- У пациентов с инфекциями мочевыводящих путей, особенно в случаях их катетеризации
- Уросепсис
- У внутривенных наркозависимых - наравне с зеленящими стрептококками - энтерококки являются одними из наиболее частых возбудителей, а потому эмпирическая антибактериальная терапия должна перекрывать оба эти возбудителя
- Холангиты и инфекции билиарного тракта
- Катетер-ассоциированные инфекции (наряду с эпидермальными стафилококками)
Существуют следующие факторы риска инфицирования энтерококками:
- Длительные и неоднократные госпитализации
- Пациенты старшего возраста
- Пациенты с иммунодефицитами различной этиологии
- Лица, страдающие хроническими заболеваниями, такими как рак и диабет
- Пациенты с установленными мочевыми катетерами
- Пациенты на гемодиализе
- Пациенты с нейтропениями
- Наличие центральных венозных катетеров и дефекты ухода за оными
- Использование в стационарах антибиотиков широкого спектра действия (срабатывает принцип «свято место пусто не бывает», и энтерококки получают селективное преимущество на поле боя, где полегла остальная микрофлора)
- Недавно прооперированные пациенты или пациенты с открытыми ранами и язвами (высокий риск внутрибольничного инфицирования)
- Пациенты с установленными дренажами, а также интубированные пациенты (риск внутрибольничного инфицирования)
Как мы можем заметить, основную роль в развитии заболеваний, вызванных энтерококками, играет человеческий, точнее ятрогенный фактор. Энтерококки, как и вся остальная кишечная микрофлора, по воздуху летать не умеют, да и ножками не ходят, а потому главное в их нераспространении - чистота наших рук и соблюдение санитарно-противоэпидемических правил, написанных, как и большинство подобных документов (например, как ПДД), кровью, причем кровью пациентов.
Аспекты лечения
Их можно разделить на лекарственные и нелекарственные.
Аспекты медикаментозного лечения
Здесь автор отступит от правила и не отправит изучать вопрос по книжкам и таблицам, а попытается расписать антибактериальную терапию более подробно. Это связано и со спецификой самого возбудителя, и со спецификой контингента, имеющего заболевания, им вызванные.
Как уже упоминалось ранее, наряду с зеленящим стрептококком, а вообще намного чаще, энтерококк является основным возбудителем инфекционного эндокардита у лиц с внутривенной наркотической зависимостью. Проще говоря, если перед вами наркозависимый, и у него эндокардит трикуспидального клапана, то первое, о чем вы должны подумать, - это энтерококк, и эмпирическую терапию назначать с учетом этого знания. Конечно, могут быть варианты в виде того же зеленящего стрептококка или даже золотистого стафилококка, но эти возбудители более присущи пациентам с несанированной ротовой полостью и на митральном клапане (зеленящий) или после кардиохирургического вмешательства (золотистый стафилококк). Также на стафилококковый, а не энтерококковый характер поражения будет намекать снимок органов грудной клетки в прямой проекции, подозрительно напоминающий решето (один раз увидев стафилококковую метастатическую пневмонию ее уже ни с чем не перепутаешь).
Чем будем лечить?
Как ни странно это прозвучит в современных условиях, но препаратами выбора будут представители аминопенициллинового ряда - ампициллин (дешевле) или амоксициллин (в разы дороже) в обязательной комбинации с аминогликозидом -гентамицином (этот дешевле) или амикацином. Поэтому если вы работаете в стационаре скорой помощи и у вас попадаются пациенты данной категории - ампициллин для инъекций крайне рекомендуется иметь на полках аптеки в достаточных количествах. Это до сих пор дешево, сердито и очень эффективно в случаях терапии энтерококковых инфекций почти любой этиологии, и главное правильно рассчитать дозу, так как аминопенициллины относятся к так называемым время-зависимым препаратам (читаем первую и вторую часть здесь).
Повторимся еще раз - аминопенициллины в данном случае должны использоваться только в комбинации с аминогликозидами ввиду их синергетического действия в отношении энтерококков и ввиду вероятности микст-инфекции у подобной категории пациентов.
Вопрос по эмпирическому использованию ванкомицина остается дискуссионным - если в случае E.faecalis его можно назначать на уровне эмпирической терапии, когда у пациента имеется документированная аллергия на пенициллины (если конечно вам покрасили мазок по Граму или ваш стационар настолько крут, что имеет свой масс-спектрометр), то в случае E.faecium даже начинать не стоит — сразу зовите специально обученного человека, пусть он думает, что дальше делать.
Как уже было выше упомянуто, цефалоспорины назначать не стоит — энтерококки к ним природно устойчивы. А для того чтобы рука потянулась к карбопенемам, вам надо иметь доказанную мульти-резистентность возбудителя.
В случае развития резистентности к ампициллину используется его защищенная форма в виде ампициллина/сульбактама в комбинации с гентамицином. Дозировки рассчитываются по ампициллину.
Если совсем не повезло и лаборатория дала мультирезистентного фекального энтерококка, то используется комбинация ванкомицин (15 мг/кг/сут) в комбинации с гентамицином (8 мг/кг/сут) под жесточайшим контролем функции почек. Кроме того, в случае мультирезистентного возбудителя может быть использована комбинация имипенема с ампициллином, если, конечно, сможете обосновать ее для страховой компании - автор обосновывала, необходимый эффект получала, пациент не только выживал, но и выздоравливал. Только призывать к такого рода схемам, описанным, в основном, в американской литературе, автор ни в коем случае не будет, особенно в нынешние неспокойные времена. Сейчас наши основные документы по назначению любого вида терапии располагаются здесь.
В случае обнаружения резистентного E.faecium препаратом выбора становится линезолид и, не побоюсь этого слова, молитва, так как срок лечения не менее 8 недель, а кто нам столько препарата выдаст, да и прогноз при применении бактериостатика как-то не очень.
- Катетер-ассоциированные инфекции: помимо удаления катетера и обязательного исследования оного в микробиологической лаборатории, установки нового катетера в новом месте, также используется ампициллин в комбинации с гентамицином (в тех же дозировках, что описаны выше) либо ванкомицин (15 мг/кг/сут), если пациент демонстрирует аллергическую реакцию на оные, либо линезолид 600 мг каждые 12 часов, либо даптомицин 6 мг/кг/сут (если сможете его добыть).
- Инфекции мочевыводящих путей- здесь предпочтение стоит отдать пероральному амоксициллину в комбинации с клавулановой кислотой дважды в день. Вызвана сия рекомендации тем, что это чаще всего эта инфекция, присущая амбулаторному этапу, будет вызвана дикой и непуганой флорой, и заодно прикроетесь от вероятной кишечной палочки как второго возбудителя. Если ситуация развилась в стационаре - смотрим пункт первый и лечим по той же схеме.
- Отдельного упоминания требует лечение ванкомицин-резистентных энтерококков, так как видят их уже практически все доктора хирургического и реанимационного профиля. Арсенал наш в этом случае крайне беден - это, по сути, только линезолид да даптомицин. Линезодид является бактериостатиком, дающим высокие риски миелосупресии и тромбоцитопении через 2 недели от начала применения, которое должно составлять не менее 8 недель, но это, по сути, единственный шанс для пациента с энтероккоковым менингитом, устойчивым к ванкомицину, так как даптомицин, который надо найти, и как-то убедить его купить (стоит он просто безбожных денег), в мозговые оболочки не проникает в виду размера самой молекулы. Можно также упомянуть о тигециклине (100 мг нагрузочная и далее по 50 мг каждые 12 часов), но он тоже стоит как самолет. Поэтому самым лучшим вариантом лечения ванкомицин-устойчивых энтерококковых инфекций является их недопущение в принципе, то есть СанПин, СанПин и еще раз СанПин. А уж если такой пациент все-таки приключился, то необходима немедленная изоляция оного в отдельную палату, а еще лучше в изолятор, чтобы от него не переинфицировать всех вокруг, если вдруг кто-то про обработку рук забудет.
На этом краткий обзор энтерококковых инфекций закончим, и из кишечной микрофлоры у нас останется только королева внтурибольничных инфекций - ее величество Klebsiella, о которой мы поговорим в одной из следующих публикаций.
Семейство Enterobacteriaceae. Часть 2
Автор: врач - клинический фармаколог Трубачева Е.С.
Сегодня мы закончим разговор о микроорганизмах из семейства Enterobacteriaceae, которое, как мы помним, является одним из самых проблематичных источников внутрибольничных инфекций, потому что возбудители умеют делиться и передавать в рамках почти всего семейства свои механизмы резистентности, и это при том, что изначально почти каждый представитель имеет природную устойчивость к целым классам антибиотиков.
Героями сегодняшнего разговора станут энтеробактеры, серрации, морганеллы. Конечно, есть и другие представители и, возможно, в постковид они начнут встречаться намного чаще, но пока нам в рамках Азбуки достаточно вышеперечисленных плюс кишечные палки и клебсиеллы, о которых мы говорили ранее.
Enterobacter spp.
Род энтеробактера включает несколько видов, но наиболее клинически значимыми из них являются:
Очень важно помнить, что энтеробактеры проявляют природную устойчивость к большому спектру антибиотиков, таким как бета-лактамы, к которым они продуцируют хромосомные AmpC бета-лактамазы, плазмидные бета-лактамазы расширенного спектра, а также карбапенемазы. Так как клинически значимые представители Enterobacter spp. обитают в желудочно-кишечном тракте человека, то основным источником инфицирования для пациента становится медицинский персонал, который просто по факту своей ежедневной работы в больнице с антибиотиками является резервуаром всевозможных антибиотикорезистентностей.
Клинически значимые аспекты
Enterobacter spp. является причиной:
- Инфекций мочевыводящих путей: катетер - или инструментально-ассоциированных (как результат эндоскопических манипуляций контаминированным инструментарием).
- Внутрибольничных пневмоний, в том числе вентилятор-ассоциированных.
- Инфекций кожи и мягких тканей, таких как раневые инфекции, инфицирование пролежней, ожоговые инфекции и послеоперационные инфекции. Кроме того в случае полимикробного характера инфицирования пролежней возможно развитие сепсиса как исхода раневой инфекции.
- Инфекций кровотока - катетер - и инструмент-ассоциированные.
- Инфекций центральной нервной системы — менингиты, чаще всего внутрибольничные, как следствие нейрохирургических вмешательств.
- Неонатальных инфекций, таких как некротический энтероколит, сепсис и менингит.
Чем лечить?
Ответ будет традиционным - лучше вообще не инфицировать, тогда не придется ломать голову, чем все это лечить. В основе терапии лежит обязательное микробиологическое исследование с определением антибиотикочувствительности.
В случае выявления представителей Enterobacter spp. при лечении тяжелых инфекций предпочтение следует отдавать комбинированной терапии, и самыми подходящими будут пиперациллин-тазобактам в комбинации с аминогликозидами или фторхинолонами. А для преодоления резистентности, вызванной бета-лактамазами расширенного спектра, можно использовать карбопенемы.
Для лечения инфекций мочевыводящих путей самым первым и наиважнейшим является удаление мочевого катетера до момента прекращения пиурии. Далее лечим либо исходя из профиля антибиотикограммы, либо ципрофлоксацином в правильно подобранной дозе, либо, как было указано выше, рассматриваем назначение нитрофуранов и фосфомицина.
Serratia spp.
Что вызывает?
- Катетер-ассоциированные инфекции и как их исход - сепсис.
- Инфекции мочевыводящих путей как следствие медицинских манипуляций необработанным инструментом.
- Раневые инфекции в послеоперационном периоде.
- Нозокомиальные пневмонии как следствие интубации.
- Септические артриты.
- Конъюнктивиты и кератиты.
- И редко вызывали остеомиелиты и эндокардиты
Терапевтические аспекты
В первую очередь про серрацию надо узнать, а значит, необходимо микробиологическое исследование. Во-вторую, вспомнить о природной устойчивости. В-третью, держать в уме то, что очень часто цефалоспорины третьего и четвертого поколения тоже не будут работать, так как посредством плазмид получают устойчивость от родственников по семейству Enterobacteriaceae, например, от родной сестры - клебсиеллы. Точно таким же образом серрация может оказаться устойчивой и к карбопенемам. К фторхинолонам резистентность так же уже давно описана.
Так чем лечить?
Лучше вообще не заражать - потому что если бак. лаборатория дает серрацию, то ниоткуда кроме как с наших рук она появиться не может, так как ни ходить, ни летать сия зверюшка до сих пор не научилась.
В случае развития тяжелых инфекций - сепсиса, вентилятор-ассоциированной пневмонии и т. п., и только при документированной чувствительности, препаратами выбора могут быть цефепим или меропенем, или ципрофлоксацин в вену в стандартных дозировках. Если чувствительность утеряна, то зовем клинического фармаколога, а если такового нет, то смотрим в сторону амикацина, пиперациллина-тазобактама и азтреонама, только помним об их побочных эффектах. Курс лечения соблюдать жизненно необходимо, чтобы зверюшка еще куда-нибудь не мутировала и новыми механизмами защиты не обзавелась. Обычно речь идет о 10-14 днях (но так как польза превышает вред, то нефротоксичность аминогликозидов со временем отступит, а ототоксичность - тут уж как повезет).
Инфекции мочеполового тракта лечим так же с учетом чувствительности, и если таковая располагает, то препаратом выбора становятся фторхинолоны, либо комбинация двух антибиотиков, например фторхинолон с карбапенемом или бета-лактам с аминогликозидом.
Эндокардиты с остеомиелитами бывают хоть и редко, но крайне метко, а потому снова сначала исследуем чувствительность, потом индивидуально в каждом случае подбираем антибиотики (а лучше зовем клинического фармаколога, пусть он мучается). И снова крайне важно соблюдение сроков лечения, для эндокардита это порядка четырех, а то и шести недель внутривенной антибактериальной терапии, а для остеомиелита не менее двух недель. Почему нельзя меньше? Потому что последует мутация и новый рецидив, а антибиотиков просто может не хватить, ибо, как и сестра-клебсиелла, серрация тоже умеет в панрезистентность.
В заключении хочется повторить, что и в этом случае проще помыть руки, чем разгребать последствия инфицирования серрацией. Мытье рук и проще, и дешевле, и, что самое главное, спокойнее.
Morganella spp.
Морганеллы будут последними представителями семейства Enterobacteriaceae, которых мы обсуждаем в рамках нашей Азбуки. Если кому-то станет интересно покопаться дальше, то к их услугам всегда будет четырехтомник по медицинской микробиологии под редакцией Лабинской, конкретно второй и третий том, в которых все очень подробно расписано, правда, чтение это для неподготовленного человека будет довольно сложным. Но вернемся к нашей морганелле.
Морганелла существует только одна - M.morganii, но имеет два подвида - M.morganii и M.sibonii, которые отличаются только по ферментации треалозы, и никакого клинического значения данное отличие не имеет.
Конечно, и морганелла умеет в природную устойчивость к антибиотикам, а именно к пенициллинам, цефалоспоринам первого и второго поколения, макролидам и ко-тримоксазолу. При этом сохраняет высочайшую чувствительность к аминогликозидам, пиперациллину, цефалоспоринам третьего и четвертого поколения, фторхинолонам и карбопенемам. То есть данную зверюшку есть чем победить.
Морганелла является представителем нормальной микрофлоры человека и самостоятельно крайне редко что-то вызывает. Этим крайне редким являются инфекции мочевыводящих путей, чему способствуют крайне пожилой возраст, длительная госпитализация, мочевой катетер и иммунодефицит любой этиологии.
В плане приобретенной антибиотикорезистентности морганелла обзавелась факторами устойчивости к фторхинолонам, что и понятно, учитывая какие именно заболевания она вызывает и чем их чаще всего лечат.
Что еще может вызывать?
- Крайне редко - сепсис, как исход инфекции мочевыводящих путей.
- Раневую хирургическую инфекцию.
- Септический артрит.
- Неонатальный сепсис и хореоамнионит.
- Менингит.
- Перикардит.
Но стоит иметь в виду, что данные ситуации крайне редки, и стоит изначально подумать не об этом возбудителе, а о том, какой за ним может прятаться в виду контаминации материала, и лучше бы все еще раз пересеять и перепроверить.
Если результат микробиологического исследования сомнений не вызывает и вы убеждены, что имеете дело с морганеллами, то препаратами выбора становятся карбопенемы, и только в случае их недоступности и документированной бактериологом чувствительности, можно посмотреть в сторону цефалоспоринов, например, цефтазидима (для которого нужна отдельная цефалоспориназа, чтобы он был инактивирован), а лучше цефтазидим-авибактама. Хотя если недоступны карбопенемы, то и Завицефте, скорее всего, взяться будет неоткуда.
Какие препараты могут быть использованы в качестве резервных? Решать этот вопрос также необходимо только после получения результата микробиологии и чувствительности в идеале по МПК, и только после этого рассматривать назначение цефепима или ципрофлоксацина, или аминогликозидов (они, к слову, в случае морганеллы могут обоснованно выступать в качестве монотерапии инфекций мочевыводящих путей).
На этом автор заканчивает обзор семейства Enterobacteriaceae и в сотый раз призывает: «Коллеги, мойте руки! Это намного проще, дешевле и быстрее, чем лечить то, что с немытых рук может упасть в пациента».
УСТОЙЧИВЫЕ К ВАНКОМИЦИНУ ЭНТЕРОКОККОВЫЕ ИНФЕКЦИИ: КЛИНИЧЕСКИЕ ПРОЯВЛЕНИЯ И ОПТИМАЛЬНОЕ ЛЕЧЕНИЕ
С момента своего открытия в Англии и Франции в 1986 году, ванкомицин- устойчивые энтерококки все чаще становятся одним из основных возбудителей внутрибольничных инфекций во всем мире. Энтерококки являются колонизаторами, со склонностью к устойчивости в больничных условиях, что обеспечивает их устойчивость 4.
По исследованиям Осипова А.Н, [3] было установлено, что 26% энтерококковых инфекций являются устойчивыми к ванкомицину как основному антибактериальному препарату для лечения этих инфекций.
Типичные клинические проявления энтерококковой инфекции устойчивой к ванкомицину включает бактериемию, эндокардит, внутрибрюшные инфекции, инфекции мочевыводящих путей, кожи, а так же инфекции центральной нервной системы.
Так как энтерококки являются колонизаторами, необходим тщательный выбор антибактериальных препаратов. Современные методы лечения, включают Линезолид, Даптомицин, Дальфопристин. Данные препараты показали высокую активность в отношении различных устойчивых к ванкомицину энтерококковых инфекций. При выборе антибактериального препарата нужно учитывать эффективность, частоту побочных эфектов, фармакокинетику, а так же возможность комбинации с другими лекарственными средствами. В данный момент на фармакологическом рынке большое количество новых перспективных препаратов используемых в лечении ванкомицин- устойчивых энтерококковых инфекций, таких как Тедизолид, Телаванцин, Далбаванцин.
Энтерококки являются устойчивыми к многим противомикробным препаратам, для этого они используют механизмы сопротивления.
Энтерококки оказывают внутренее сопротивление с помощью с пенициллин- связывающих белков с низким сродством к этим агентам.
Сопротивление высокого уровня энтерококков достигается за счет двух механизмов: производство низкоаффинные PBP5 и производства β- лактамаз. Эти механизмы могут привести к гидролизу белка клеточной стенки.
Устойчивость к аминогликозидам.
Энтерококки по своей природе устойчивы к низким уровням аминогликозидов из- за снижения клеточной проницаемости этих агентов , но это можно преодолеть с добавления активного агента, что увеличивает проникновение аминогликозидов в клетку.
Устойчивость к гликопептидам.
Бактериальные клеточные стенки изготовлены из пептидогликана, которая образуется в клеточной стенки из пентапептидных предшественников. Он образуеся путем трансгликозилирования, образуя поперечные сшивки от транспептидации для укрепления клеточной стенки. Гликопептиды, такие как ванкомицин и тейкопланин оказывают свое антибактериальное действие путем связывания с высокой аффинностью к d-Ala - d-Ala -концами пентапептида для того, чтобы ингибировать синтез пептидогликана. Устойчивость гликопептодов возникает тогда, когда формируются низкоаффинные пентапептидные предшественники D-Ala - D- Lac или D-Ala - D- Ser и высоким сродством к предшественникам D-Ala - D-Ala. [1]
Клиническая картина энтерококковой инфекции.
Бактеремия без эндокардита является частым проявлением энтерококковой инфекции, особенно у ослабленных больных. Бактериемию чаще выделяют из мочевых катетеров, а так же из ожоговых ран, желчного пузыря.
Энтерококки являются второй наиболее распространенной причиной инфекционного эндокардита 20% от всех случаев. Наиболее распространенные клинические проявления лихорадка, потеря веса, общее недомогание, узлы Ослера, петехии, и пятна Рота.
Сочетание β-лактамных атибиотиков и аминогликозидов.
Монотерапию ампициллином следует проводить для ампициллин- восприимчивых энтерококков. Для бактериемии, вызванной ампициллин- резистентными этерококками, следует проводить терапию высокими дозами ампициллина в сочетании с аминогликозидами . [2]
1. Билимова С.И. Характеристика факторов персистенции энтерококков. Журн. микробиол. 2000, 4: 104, 105.
2. Бондаренко В.М. Поликомпонентные пробиотики: механизм действия и терапевтический эффект при дисбиозах кишечника. Фарматека. 2005, 20 (115): 46-54.
3. Габриэлян И.Н., Горская Е.М., Спирина Т.С., Преображенская Т.Б., Осипов А.Н. Энтерококки как возбудители инфекционных послеоперационных осложнений. Журн. микробиол. 2007, 4: 50-53.
Судаков О.В. Комплексный подход к лечению хронической обструктивной болезни легких / О.В. Судаков, Э.В. Минаков, Е. А. Фурсова // ГОУВПО "Воронежский гос. технический ун-т". Воронеж, 2010. -195 с.
Антибиотики для лечения энтерококковых (Enterococcus spp.) раневых инфекций. Резистентность к ванкомицину
Медицинская микробиология:
Резистентность энтерококков к антибактериальным препаратам
Большинство видов энтерококков природно резистентны к разным антибиотикам — β-лактамным, линкозамидам, аминогликозидам, ингибиторам обмена веществ с участием фолиевой кислоты, триметоприму и сульфаниламидам. Резистентность к β-лактамным препаратам обязана низкому аффинитету пенициллин-связывающих белков (ПСБ), образуемых некоторыми видами энтерококков. Минимальные подавляющие (ингибирующие) концентрации (МИК) пенициллинов могут в 2 раза и более превышать уровень 64 мкг/мл в зависимости от специфичности антибиотика, вида энтерококка или даже штамма. При более высоких значениях МИК для иолусинтетических пенициллинов и цефалоспоринов они клинически неэффективны.
Энтерококки, резистентные к аминогликозидным препаратам, имеют значения МИК от 8 до 250 мкг/мл в зависимости от аминогликозида, вида энтерококка или даже от штамма, что связано с ограничением транспорта препарата через клеточные мембраны. Природная резистентность энтерококков к β-лактамным антибиотикам, так же как и к аминогликозидам, может меняться при использовании комбинации антибиотиков (β-лактамных с аминогликозидами). Присутствие ингибитора синтеза клеточной стенки, такого как β-лактам, приводит к повышению захвата аминоглико-зидов энтерококками, что способствует их гибели. Приобретение высокого уровня резистентности ко всем клинически значимым аминогликозидам может привести к элиминации достигнутого синергетического эффекта в лечении многих вызываемых энтерококками инфекций.
Энтерококки также природно устойчивы к линкозамидам, таким как линкоми-цин и клиндамицин, со значениями достигаемого уровня МИК до 100 мкг/мл.
Природная резистентность энтерококков к ингибиторам обмена веществ с участием фолиевой кислоты обусловлена их способностью усваивать экзогенно тимидин, тимин и фолаты, такие как фолиевая кислота, гидрофолаты и тетрагидрофолаты.
а) Повышение уровня резистентности энтерококков к амидогликозидам. Описаны три типа ферментов, модифицирующих аминогликозиды, включая: фосфотрансферазы (APHs), ацетилтрансферазы (AACs) и нуклеотидилтрансферазы (ANTs), которые соответственно осуществляют фосфорилирование гидроксильной группы на аминогликозиде в присутствии АТФ-ацетилирования аминогрупп, используя коэнзим А в качестве донора, и аденилирование гидроксильной группы АТФ.
Приобретение этих ферментов обычно кодируется плазмидами, в результате чего возникает высокий уровень резистентности энтерококков к аминогликозидам, т.е. МИК этих антибиотиков доходит до 2000 мкг/мл и даже может быть выше 40 000 мкг/мл.
Высокий уровень устойчивости энтерококков к стрептомицину наблюдался более чем у 50% штаммов, выделенных от больных в середине 50-х годов прошлого столетия. Были описаны два типа ферментов, модифицирующих стрептомицин. Мутации в рибосомальной субъединице 30S приводят к снижению связывания стрептомицина с рибосомой, что, в свою очередь, способствует повышению уровня МИК препарата до 128 000 мкг/мл.
Большинство клинически значимых энтерококковых генов, приводящих к модификации активности аминогликозидов, являются aac (6)-Iе-Iа, которые кодируют бифункциональный энзим ААС (6 )-АРН (2), обусловливающий резистентность к гентамицину, тобрамицину, амикацину, канамицину, нетилмицину и дибекацину. Этот ген был впервые описан при определении высокого уровня резистентности к гентамицину у штамма E. faecalis, который также оказался резистентным к канамицину и тобрамицину, но не к стрептомицину.
Описаны более 90% штаммов, устойчивых к гентамицину, которые кодируются бифункциональными энзимами и обеспечивают резистентность к гентамицину, а также к другим аминогликозидам.
б) Повышение уровня резистентности энтерококков к бета-лактамам. Выделенный в 1981 году штамм Е. faecalis НН22 был первым энтерококком, проявляющим β-лактамазную активность. Второй такой же штамм энтерококка был обнаружен и описан в США в 1983 году. Вскоре штаммы Е. faecalis, образующие β-лактамазу, были выделены в 4 странах. Многие их этих штаммов были выделены вне- и внутрибольнично. Даже среди изолированных штаммов, которые не были клональными, β-лактамазная активность всегда ассоциировалась с высоким уровнем резистентности к гентамицину, и только единственный штамм Е. faecalis, образующий β-лактамазу, экспрессировал высокий уровень резистентности ко всем аминогликозидам. Высокий уровень резистентности энтерококков к β-лактамным антибиотикам, в особенности к пенициллинам, может также быть обязан сверхэкспрессии низкого аффинитета пенициллин-связывающих белков (ПСБ), и/или мутациям ПСБ в структурном гене, которые снизили их аффинитет к пенициллинам еще в большей степени. Спонтанные мутации у штаммов Е. faecalis и E. faecium также способны приводить к образованию высокого уровня аффинитета ПСБ у штаммов с ранее низким его уровнем.
в) Резистентность энтерококков к гликопептидным антибиотикам. Первый штамм Е. faecalis, резистентный к гликопептидным препаратам, был выделен в 1986 г. Он содержал плазмиду, которая обеспечивала резистентность к ванкомицину и тейкопланину. Было установлено, что эта резистентность была обязана генам, закодированным на транспозоне Тп 1546, и продукты этих генов явились результатом синтеза скорее пептидогликанового предшественника, чем нормального пептидогликана, заканчивающегося D-Ala-D-Ala.
Этот оригинальный пептидогликановый фенотип резистентности в исследовании стал известен как фенотип A (VanA). Дополнительно были описаны еще пять фенотипов от VanB до VanE (табл. 1.3.2). Штаммы Е. faecalis фенотипа VanA экспрессируют высокие уровни резистентности к гликопептидным препаратам — ванкомицину и тейкопланину. Штаммы энтерококков фенотипа VanB экспрессируют вариабельные уровни резистентности к ванкомицину, но эти штаммы чувствительны к тейкопланину. В этом случае резистентность к ванкомицину обуславливается геном van В, более часто локализованном на хромосоме, но он может также присутствовать на плазмиде. Кластер генов vanB может также быть локализован на сложном транспозоне Тп 1547 внутри большого хромосомно-конъюгативного элемента. Фенотип VanB в основном ассоциирован со штаммами Е. faecalis, E.faecium и иногда с Е. casseliflavus и Е. gallinarum.
Фенотип VanC резистентности энтерококков не является приобретенным, а скорее может быть природным у штаммов Е. gallinarum, Е. casseliflavus и Е. flavescens. Для фенотипа VanD, выявленного в штаммах Е. faecium, характерен основной тип резистентности к ванкомицину и тейкопланину. Ген vanD, локализованный только на хромосоме, но может быть также трансмиссивным. Пептид, имеющийся в VanD, как и в штаммах фенотипа А, заканчивается D-лактатом.
Фенотип VanЕ в штамме Е. faecalis, детерминированный на хромосоме, обеспечивает низкий уровень резистентности к ванкомицину и чувствительности к тейкопланину. Этот фенотип обязан своим возникновением индуцированному ванкомицином синтезу пептидогликана, заканчивающегося пептидом D-Ala-D-Ser.
г) Гены, обеспечивающие резистентность энтерококков к гликопептидам. Резистентность к гликопептидам у энтерококков включает двухкомпонентные системы, в которых строение клеточной системы изменяется от предшественника пептидогликана D-Ala-D-Ala (чувствительность к ванкомицину) до D-Ala-D-lactate (D-Lac), который имеет в 1000 раз меньший аффинитет для ванкомицина, в то время как D-Ala-D-Ser имеет семикратное снижение аффинитета для ванкомицина, тем самым снижая чувствительность мишени. Генами, включенными в эту двухкомпонентную систему, являются vanS/vanR. VanS — сенсор-киназа, активированная в ответ на ванкомицин, в результате приводит к активированию D-Lac- или D-Ser- предшественника пептидогликана и репрессии D-Ala-D-Ala. Шесть кластеров генов, связанных с резистентностью к гликопептидам, были идентифицированы в энтерококках разных видов: от van А до van G.
Кластерами генов vanC, vanА и vanВ кодируются три главных типа резистентности. Природная резистентность фенотипа VanC является специфичной для Е. gallinarum, Е. casseliflavus и Е. flavescens, и оперон vanC, локализованный на хромосоме, не является трансмиссивным. Оперон резистентности vanA включает в себя семь генов (vanН, vanA, vanX, vanR, vanS, vanY и vanZ), которые приобретает через транспозон Tn1546.
д) Резистентность энтерококков к фторхинолонам. Был изучен механизм резистентности клинических штаммов Е. faecalis и Е. faecium к фторхинолонам. Для обоих видов высокий уровень резистентности связан с заменой аминокислот в детерминантной области фторхинолоновой резистентности. МИК ципрофлоксацина в отношении 10 изученных штаммов Е. faecium варьирует от 32 до более 256 мкг/мл.
е) Резистентность энтерококков к прочим антибиотикам. Резистентность энтерококков к некоторым антибиотикам обнаруживали в штаммах, выделенных от людей еще в первой половине 50-х годов прошлого столетия.
Более 50 % штаммов энтерококков, выделенных от больных в городской больнице Бостона в 1953-1954 гг. были резистентны к стрептомицину и тетрациклину, а 96 и 25 % штаммов были резистентны к хлорамфениколу и эритромицину соответственно. Не было обнаружено ни одного штамма, резистентного к ампициллину, гентамицину или ванкомицину.
Среди штаммов энтерококков, изолированных от больных Вашингтона и его окрестностей в середине 50-х годов прошлого столетия, половина имела минимальный уровень чувствительности к эритромицину, но не к линкомицину.
Более общий механизм резистентности к эритромицину среди энтерококков и других грамположительных бактерий включает деметилирование адениновых остатков в 23S рРНК внутри рибосомальной субъеденицы 50S.
Частота случаев резистентности энтерококков к тетрациклину варьировала между 50 и 80 % и, как в случае с резистентностью к хлорамфениколу, зависела от географического расположения и времени выделения штаммов. У энтерококков выявлено два механизма устойчивости к тетрациклину — активный выброс (эффлюкс) и рибосомальная защита. Энергозависимый эффлюкс-механизм, связанный с плазмидами, обеспечивает ген tetL, в то время как ген tetM ответственен за защиту рибосом. Ген tetM был обнаружен в энтерококках, а также в грамотрицательных и грамположительных бактериях. Обычно в штаммах энтерококков ген tetM связан с хромосомой и часто может быть локализован на транспозоне, но он может также присутствовать и на плазмиде.
ж) Резистентность энтерококков к линезолиду. Линезолид — единственный представитель нового класса антибактериальных препаратов — оксазолидонов, предназначенных для клинического лечения некоторых бактериальных инфекций, вызываемых грамположительными микроорганизмами, включая инфекции, обусловленные резистентными к ванкомицину штаммами энтерококков.
Оказалось, что резистентность штаммов энтерококков к линезолиду развивается крайне редко. Впоследствии была собрана коллекция устойчивых к ванкомицину клинических штаммов энтерококков, чувствительных к линезолиду, которые были подвергнуты серийным пассажам с удвоенными концентрациями антибиотиков. В результате были выявлены резистентные к линезолиду варианты энтерококков. Штаммы Е. faecalis начали проявлять резистентность к линезолиду через три пассажа, их МИК к этому антибиотику достигли лишь уровня от 8 до 16 мкг/мл.
Значения МИК90 этого препарата для различных видов энтерококков, независимо от устойчивости к препаратам различных классов, составляет 4,0 мкг/мл. Линезолид применяется внутривенно и внутрь и не применяется внутримышечно.
Читайте также:
- Причины и возбудитель дизентерии. Механизмы развития дизентерийной инфекции
- Показания к дистальной остеотомии малоберцовой кости на уровне перелома при неправильном сращении
- Осложнения эхинококкоза легких. Операции при эхинококкозе легкого
- Эмбриогенез спинного мозга (этапы развития и формирования)
- Синдром Нотнагеля (Nothnagel)
